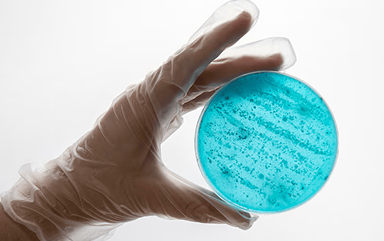
Lab technician extracting DNA

Our DNA sequencing-based detection of the genetic markers for infectious disease, congenital disease, and antimicrobial resistances affords healthcare providers the ability to make precise decisions about patient care.
- Rapid Disease Detection and Surveillance
- Antimicrobial Resistance/Sensitivity Detection and Surveillance
- Genetic Screening